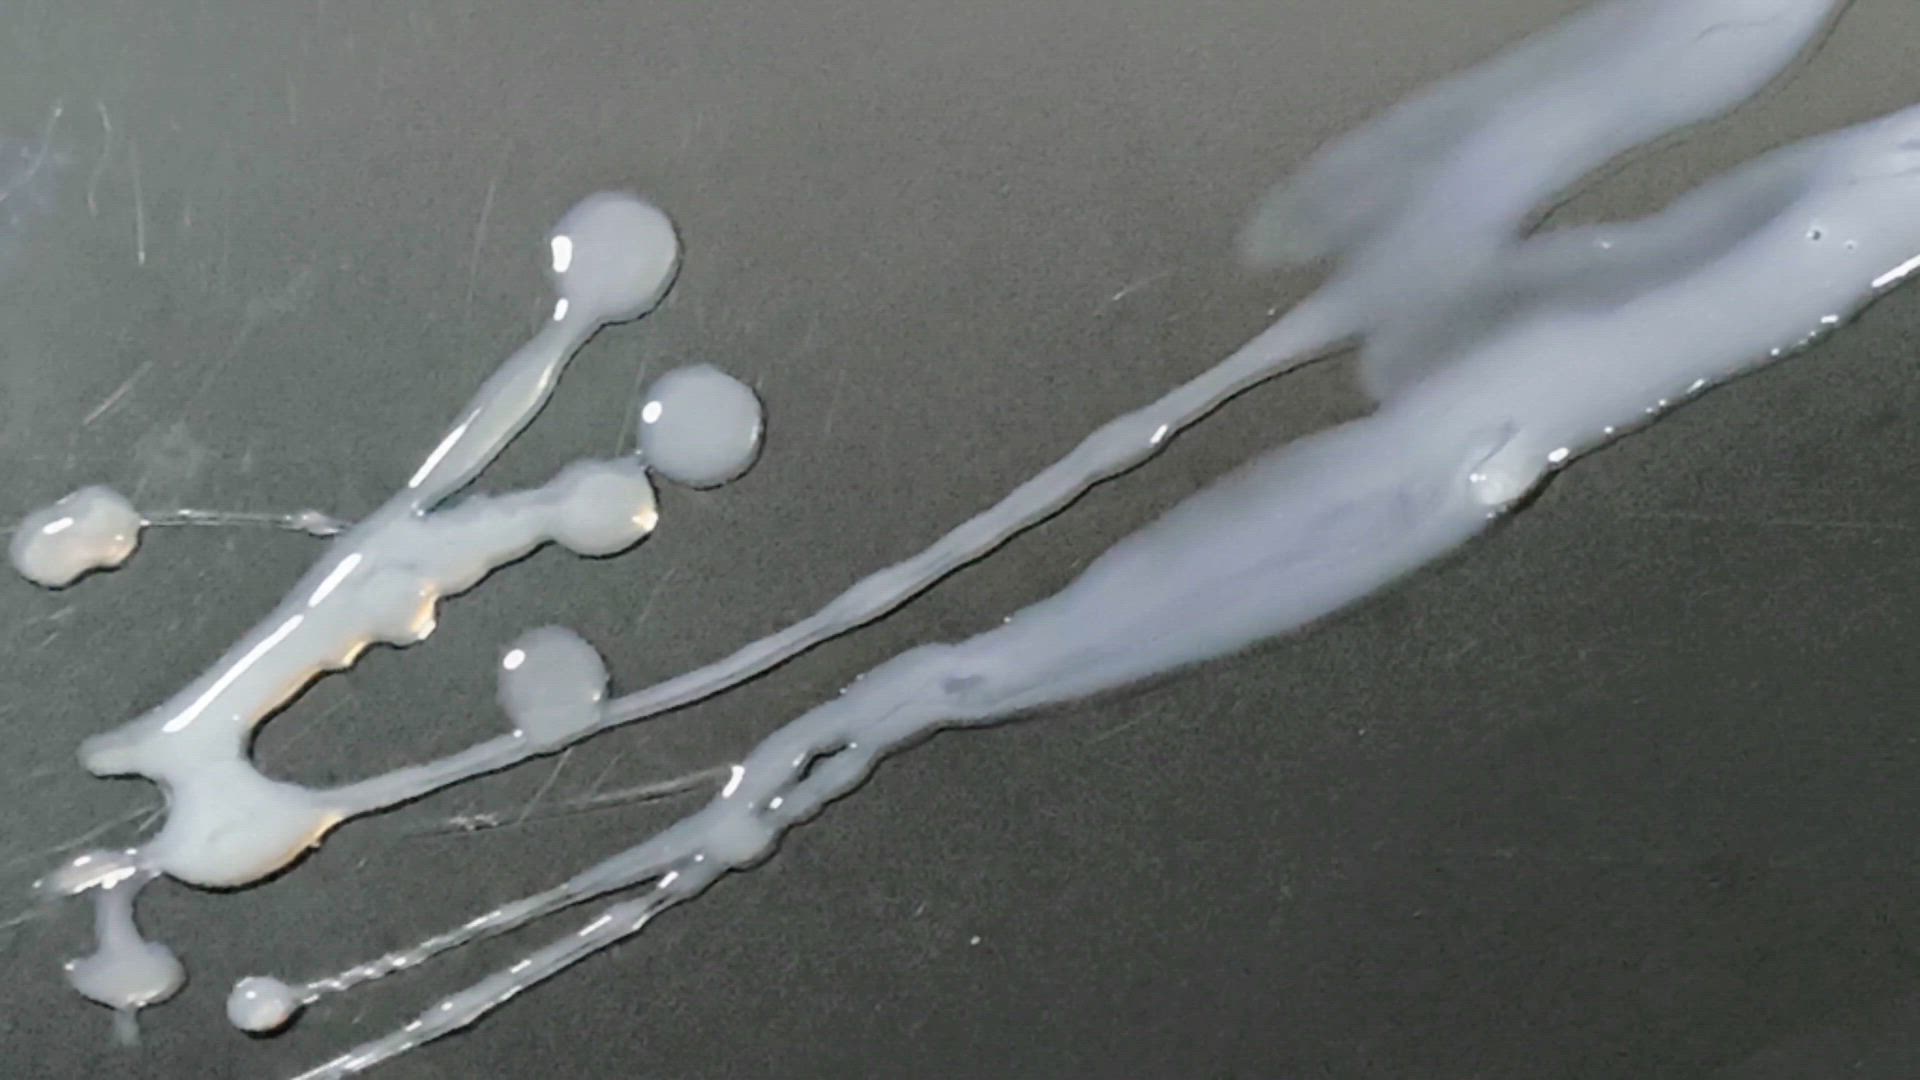

Still producing so much goodness out of her girl dick, with all the jelly bits what a treat!
SC030 - 27H, 2H
Still producing so much goodness out of her girl dick, with all the jelly bits what a treat!
Comments
0 commentsNo comments yet. Be the first to comment!